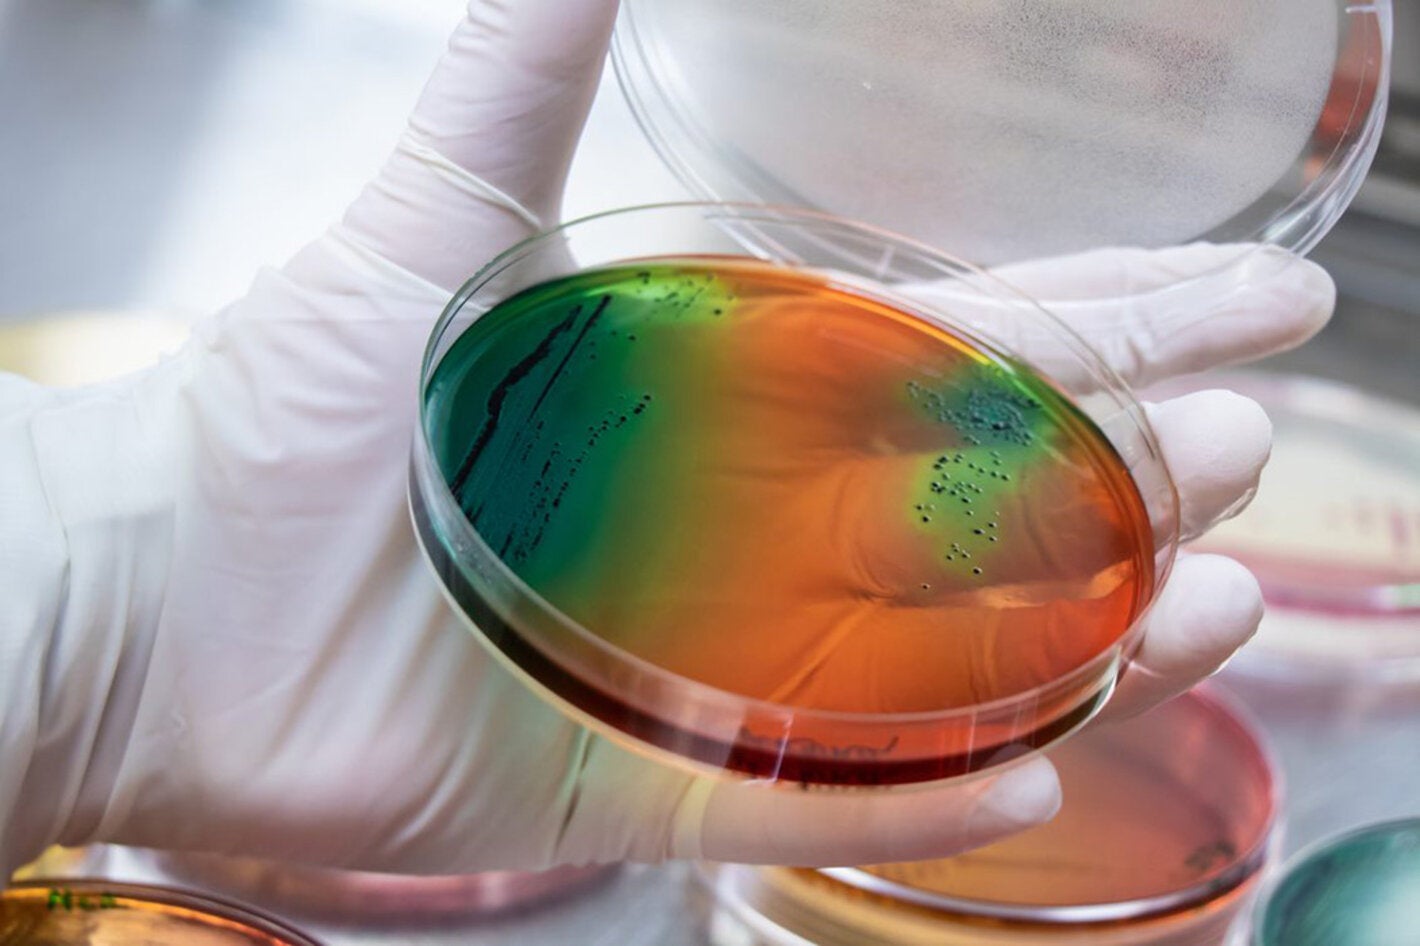
colorful image of a petri dish

Bogotá, 3 de marzo de 2021 (OPS/OMS) - Más de 700 mil muertes anuales se presentan cada año en el mundo debido a infecciones por bacterias resistentes a los antimicrobianos, lo que se ha convertido en un serio problema de salud pública mundial, que podría ocasionar 10 millones de muertes en los próximos 25 años y dejar pérdidas económicas que superarían los 100 billones de dólares para 2050.
Aunque se trata de un fenómeno que aparece de forma natural con el paso del tiempo, en las últimas décadas se ha visto un crecimiento acelerado de la resistencia antimicrobiana (RAM), debido a múltiples factores que involucran acciones como el uso inadecuado de los antibióticos, tanto en salud humana como en sanidad animal; la transferencia de bacterias resistentes de los animales a los humanos, por contacto directo o a través de los alimentos, y la contaminación de fuentes de agua con medicamentos antimicrobianos y residuos de estos, como explicaron los expertos durante la Semana Mundial de Concienciación sobre el Uso de Antimicrobianos de la estrategia ‘Una sola salud’.
Un desafío mundial que demanda la atención de todos los sectores de la sociedad: organizaciones nacionales e internacionales, investigadores y comunidad científica, académicos, personal sanitario, instituciones, ministerios, gobiernos y población en general.
Proyecto colaborativo
Para enfrentar esta realidad, detener la progresión y mitigar el impacto de la RAM, la Organización Panamericana de la Salud (OPS), la Organización de las Naciones Unidas para la Alimentación y Agricultura (FAO) y la Organización Mundial de Sanidad Animal (OIE) vienen trabajando, de forma unificada y coordinada, en una alianza tripartita a la que se sumó la Unión Europea (UE), que tiene una experiencia interesante con diversas acciones para combatir la RAM.
Así nace el proyecto ‘Trabajando juntos para combatir la resistencia a los antimicrobianos’ bajo el enfoque de ‘Una salud (One health)’, teniendo en cuenta que la salud humana y la sanidad animal son interdependientes y están vinculadas a los ecosistemas en los cuales coexisten.
Se trata de un proyecto de cooperación para que los países seleccionados, en este caso siete de América Latina, puedan fortalecer sus planes de acción para el control de la RAM. Esos países son:
- Argentina
- Brasil
- Chile
- Colombia
- Paraguay
- Perú
- Uruguay
La iniciativa contempla un trabajo desde el año 2020 hasta el 2023, durante los cuales se adelantarán diferentes acciones, como brindar asistencia técnica, capacitación, espacios para el intercambio de experiencias a partir de los avances que presenta cada uno de los países en la lucha contra la RAM, y vigilancia a patógenos centinela, soportados en cuatro pilares fundamentales:
- Apoyar el desarrollo y la evaluación de la implementación de los Planes de Acción Nacionales (PAN) de RAM, bajo el enfoque de ‘Una salud’.
- Fortalecer la vigilancia y el control de la RAM y del uso de antimicrobianos humanos y veterinarios de conformidad con las normas internacionales.
- Estimular al sector privado para que participe en el control de la RAM, mediante la consolidación de alianzas público-privadas.
- Fortalecer la investigación y la innovación sobre la RAM y las alternativas a los antibióticos.
Esto, porque como ha enfatizado la doctora Gina Tambini, representante de la OPS/OMS Colombia, se trata de “un gran desafío mundial y de ahí la importancia de trabajar juntos; porque esta es una problemática transversal que afecta la salud humana, la sanidad animal y medioambiental. Nunca antes había sido tan importante como ahora el conocimiento y el entrenamiento en el uso apropiado de los antibióticos”.
Problema que crece
En el documento ‘Trabajando juntos para combatir la resistencia a los antimicrobianos’ se define la RAM como un “fenómeno natural de cambios genéticos en microorganismos, como las bacterias, virus, parásitos y hongos, que les permiten ser cada vez más resistentes a la acción de los fármacos (antibióticos, antifúngicos, antiparasitarios, entre otros).
El mal uso y abuso de antibióticos, el control deficiente de las infecciones, las condiciones sanitarias inapropiadas y la manipulación inadecuada de los alimentos, fomentan la propagación de microorganismos resistentes a los antimicrobianos y, como resultado, hoy se presentan enfermedades infecciosas que se hacen más difíciles de tratar o para las que el espectro de medicamentos se reduce cada vez más.
“Infecciones comunes y potencialmente mortales, como neumonía, infecciones postoperatorias, así como VIH, tuberculosis y malaria, son cada vez más difíciles de tratar debido a la resistencia a los antimicrobianos. Si este fenómeno no se controla puede traer consecuencias signicativas a nivel social, económico y de seguridad sanitaria, que pueden perjudicar el desarrollo de los países”, dicen los expertos de ‘Trabajando juntos para combatir la resistencia a los antimicrobianos’, quienes advierten también que la RAM “pone en peligro los Objetivos de Desarrollo Sostenible”.
Una problemática tan seria y grave que, en palabras de la doctora Pilar Ramón Pardo, coordinadora del Programa Especial para la Lucha contra la Resistencia Antimicrobiana de OPS/OMS, “amenaza con acabar con un siglo de avances médicos”.
Organismos de apoyo
En el documento ‘Trabajando juntos para combatir la resistencia a los antimicrobianos’ bajo el enfoque de ‘Una salud’, se resalta el apoyo que cada uno de los organismos mundiales brindará a los países en la lucha contra la RAM.
Organización Panamericana de la Salud (OPS): Nació en 1902, su sede central está en Washington D.C. (Estados Unidos) y es la Oficina Regional para las Américas de la Organización Mundial de la Salud (OMS). Promueve el intercambio de experiencias y aboga por mejores prácticas y acciones colaborativas entre países; brinda apoyo técnico y liderazgo a los estados miembros en su compromiso por combatir la RAM e implementar Planes de Acción Nacionales (PAN) desde el enfoque ‘Una salud’. Es el enlace entre los países seleccionados y la UE, y se encarga del manejo de los recursos.
Organización de las Naciones Unidas de la Alimentación y la Agricultura (FAO): Organismo especializado de la ONU, con oficinas centrales en Roma (Italia). Nació en 1945. Apoya a los gobiernos y a los productores de alimentos para que adopten medidas destinadas a minimizar el uso de antimicrobianos y reducir la resistencia a los mismos, teniendo en cuenta las necesidades de los sectores de la alimentación y la agricultura. En calidad de organización multidisciplinaria, promueve la contención de la RAM a lo largo de la cadena agroalimentaria.
Organización Mundial de Sanidad Animal (OIE): Con sede en París, Francia, nació en 1924. Elabora normas mundiales y promueve el uso responsable y prudente de los agentes antimicrobianos, el bienestar animal y las buenas prácticas de producción de los animales terrestres y acuáticos, para preservar la eficacia terapéutica y prolongar el uso de los antimicrobianos, tanto en animales como en humanos. Además, promueve la integración de los sectores público y privado.
Unión Europea. Nació en 1993, con el fin de promover la integración y gobernanza en común de las naciones de Europa. Aporta a este proyecto recursos económicos anuales, más su experiencia y conocimientos sobre RAM, a través de sus Direcciones Generales de Salud y Seguridad Alimentaria y de Investigación e Innovación, así como de sus agencias: Centro Europeo para el Control y Prevención de Enfermedades (ECDC), Autoridad Europea de Sanidad Sanitaria (EFSA) y Agencia Europea de Medicamentos (EMA).



